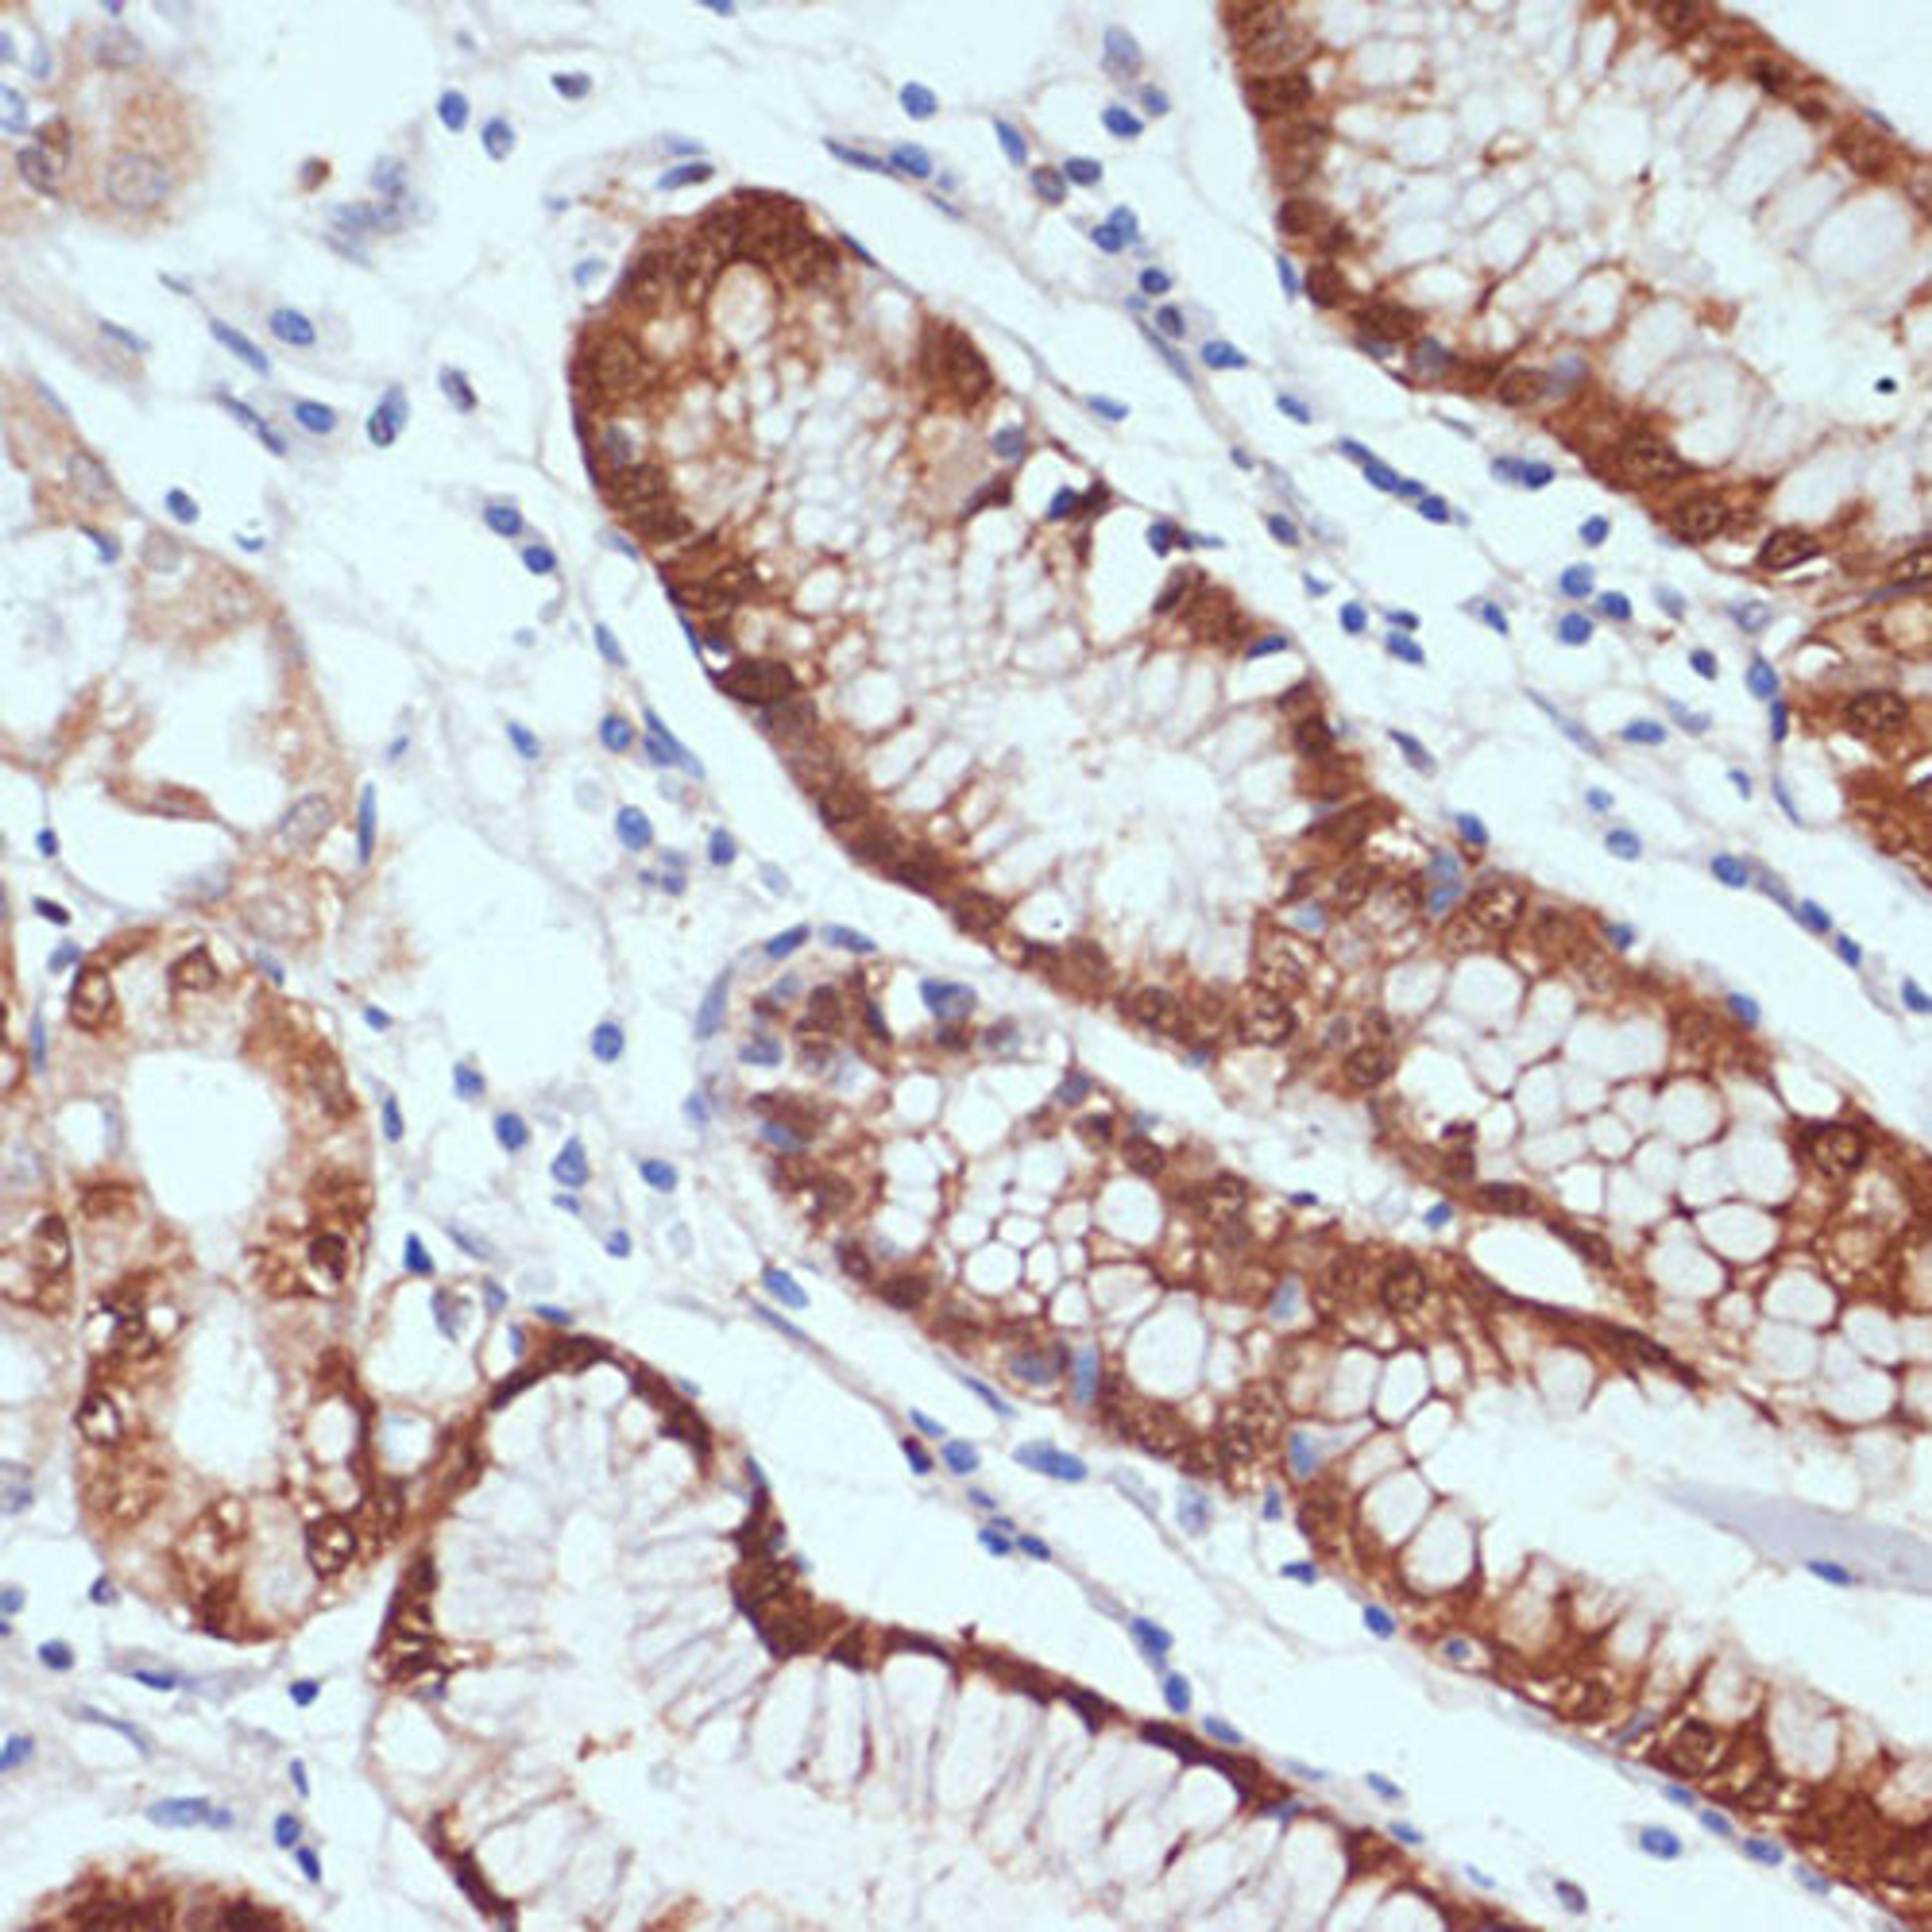
Immunohistochemistry - CXCL12 antibody (A1325)

Product & ReviewsAntibodies
CXCL12 Rabbit pAb
Product Details
- Cat. No.
- A1325
- Type
- Primary Antibody
- Clonality
- Polyclonal
- Host
- Rabbit

The supplier does not provide quotations for this antibody through SelectScience. You can search for similar antibodies in our Antibody Directory.
Description
This antimicrobial gene encodes a stromal cell-derived alpha chemokine member of the intercrine family. The encoded protein functions as the ligand for the G-protein coupled receptor, chemokine (C-X-C motif) receptor 4, and plays a role in many diverse cellular functions, including embryogenesis, immune surveillance, inflammation response, tissue homeostasis, and tumor growth and metastasis. Mutations in this gene are associated with resistance to human immunodeficiency virus type 1 infections. Multiple transcript variants encoding different isoforms have been found for this gene.
Biological Information
- Clonality: Polyclonal
- Host: Rabbit
- Reactivity: Human, Mouse, Rat